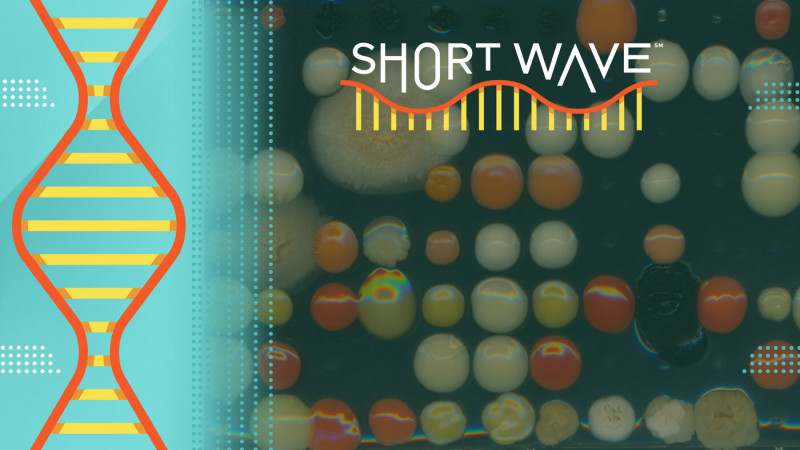
Link Preview

NPR
News source#TrafficSafety #ElderlyDrivers #RoadSafety

#optimism #resilience #mentalhealth

#politics #democracy #humanrights

#ImmigrationLaw #DueProcess #Deportation

#StudentLoans #TreasuryDepartment #EducationPolicy

#TanningBeds #SkinCancer #PublicHealth

#Autism #Vaccines #HealthPolicy

#IranWar #USPolitics #MilitaryIntervention

#MigrantWorkers #MiddleEast #Dubai

#NewsUpdates #CurrentEvents #InternationalRelations

#Iran #Israel #MiddleEastConflict

#FederalReserve #Inflation #Economy

#WorldBaseballClassic #Venezuela #BaseballChampionship

#USSGeraldRFord #MilitaryDeployment #NavyOperations

#Politics #InternationalRelations #Assassination

#Cannabis #MentalHealth #Research

#Counterterrorism #USForeignPolicy #IranConflict

#USPS #PostalService #FinancialCrisis

#Immigration #PalestinianRights #Activism

#TemporaryProtectedStatus #SupremeCourt #ImmigrationPolicy

#SleepingSickness #PublicHealth #Acoziborole

#Autism #Leucovorin #Healthcare

#AcademyAwards #ConanOBrien #FilmIndustry

#SevereWeather #StormWarnings #WeatherImpact

#WestBank #IsraeliPalestinianConflict #HumanRights